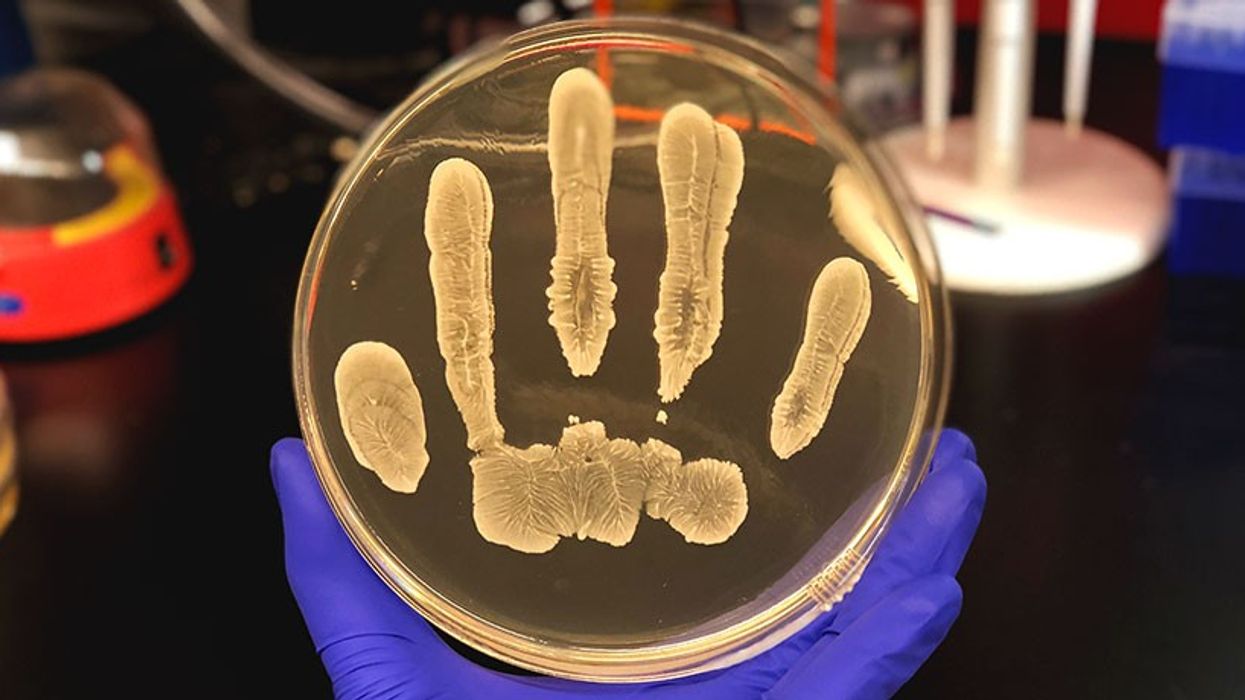
2018/12/022718_AC_skin-bacteria_feat.jpg

Bakteri i cili jeton në lëkurë gjithsecilin nga ne e ka bërë rezistues ndaj ilaçeve dhe në raste të këtilla mund të jetë fatal
Bakteri është i ngjashëm me superbakterin MRSA, i cili tashmë një kohë të gjatë është rezistues ndaj antibiotikëve.Staphylococcus epidermidis jeton, zakonisht pa ndikim negativ, në lëkurën e secilit prej nesh, mirëpo mund të futet në organizëm edhe pas operacionit dhe të shkaktojë infeksione serioze, transmeton Telegrafi.
Shkencëtarët kanë identifikuar forma shumë më të rrezikshme të baktereve në lëkurën e njerëzve të cilët janë infektuar pas operacionit.
Bakteri vazhdimisht gjen mënyra të reja që të mbijetojë në sipërfaqen e lëkurës së secilit prej nesh, ndërkaq llojet rezistuese ndaj ilaçeve dhe shumë të rrezikshme munden lehtë dhe shpejt të përhapen.
– Staphylococcus epidermidis është patogjen vdekjeprurës. Ende injorohet kimikisht, sepse shumë shpesh supozohet që është fjala për infeksionin nga instrumentet laboratorike dhe merret si rrezik i cili me vete bart çdo intervenim. Infeksionet pasoperacionale mund të jenë shumë të rrezikshme dhe vdekjeprurëse, thotë profesori Sem Sheppard.
Për të penguar vdekjen nga ky bakter i rrezikshëm është e domosdoshme të përcaktohet cilët janë ata pacientë më të rrezikuar dhe kanë aplikuar masat më rigoroze higjienike tek ata.
Një numër i vogël i pacientëve të shëndetshëm bart këtë bakter në lëkurën e vet, andaj rrezikojnë që të infektohen pas operacionit.
Infeksionet e këtilla vështirë diagnostikohen, prandaj ekziston shpresa që gjenet të cilat janë të lidhura me këtë sëmundje mund të tregojnë se kush është më i ekspozuar ndaj rrezikut më të madh. /Telegrafi/




















































